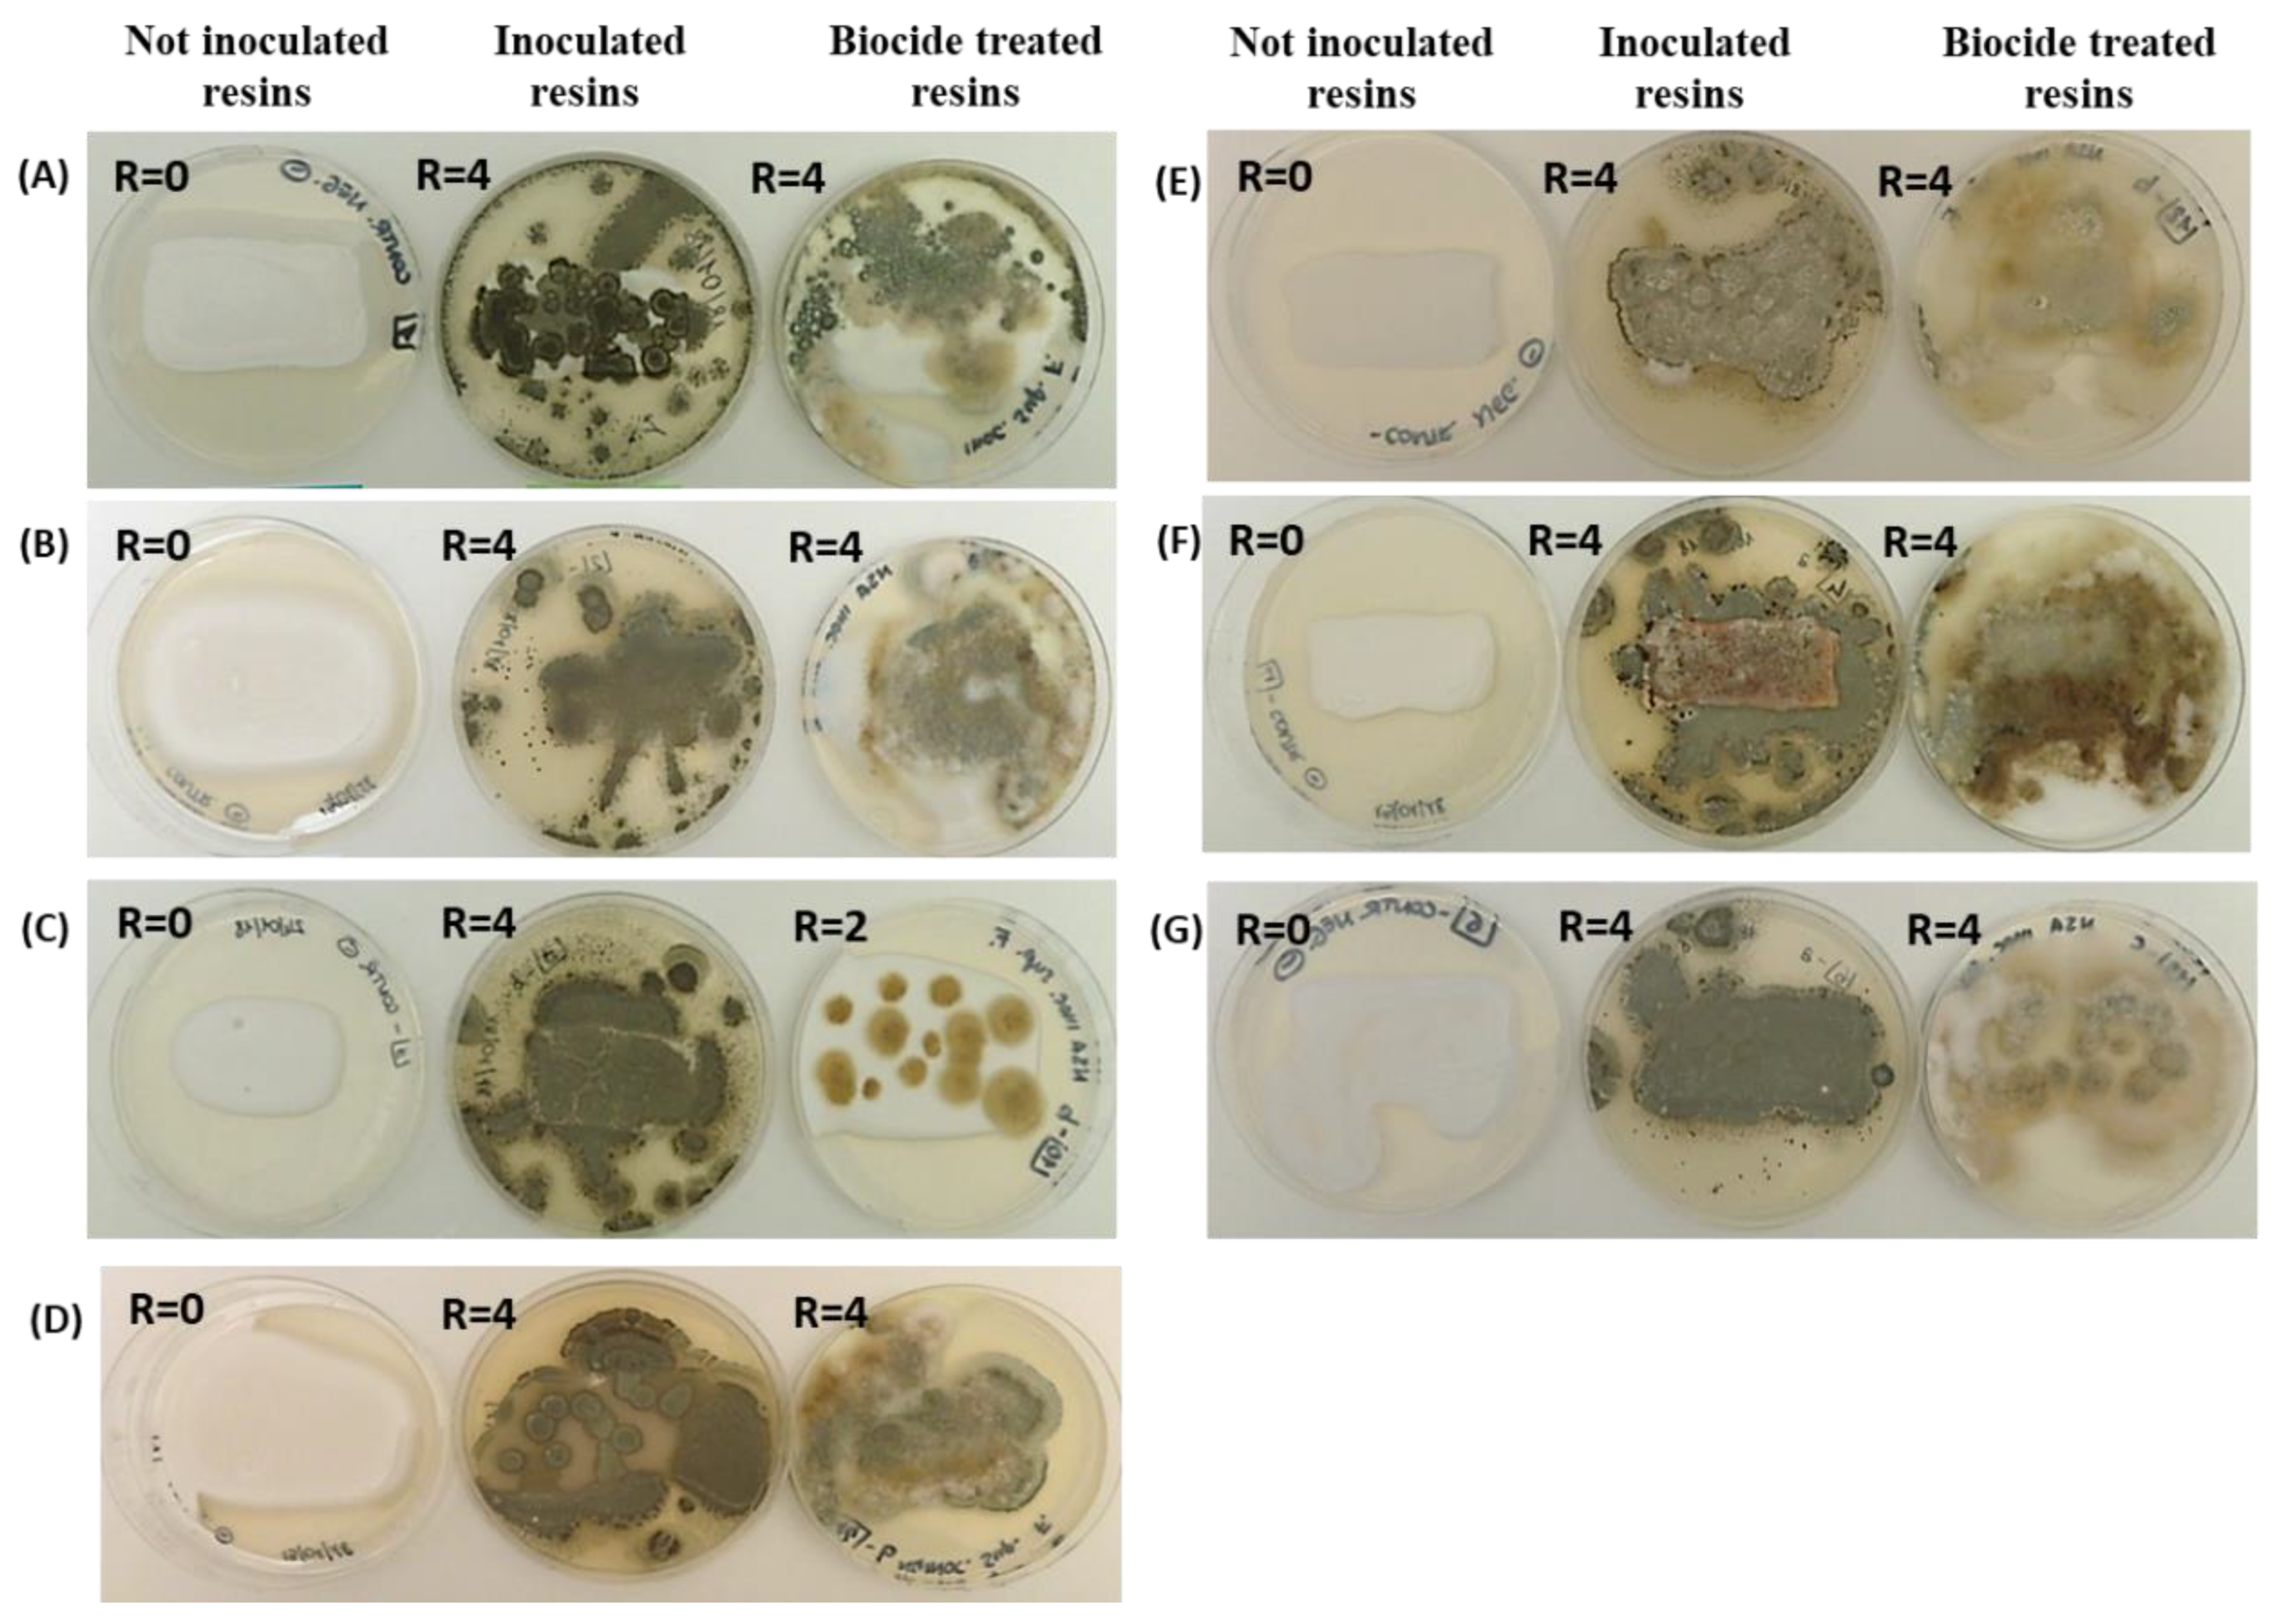
Ijms 23 11725 g001

A Multidisciplinary Approach in Examining the Susceptibility to Microbial Attack of Polyacrylic and Polyurethane Resins Used in Art Restoration
Abstract
1. Introduction
2. Results
2.1. Resins’ Susceptibility to Microbial Attack
2.2. ESEM
2.3. FTIR Analysis
2.3.1. Polyacrylic Resins (AC 012, AC 013, AC P1 and AC 32)
2.3.2. Polyurethane Resins (PU H6, PU GS and PU MW2)
3. Discussion
4. Materials and Methods
4.1. Polyacrylic and Polyurethane Resins
4.2. Microbial Strains and Culture Conditions
4.3. Inoculum Preparation
4.4. Simulated Microbial Attack
4.5. Environmental Electron Scanning Microscope (ESEM)
4.6. Fourier-Transform–Infrared-Spectroscopy (FT-IR)
5. Conclusions
Supplementary Materials
Author Contributions
Funding
Institutional Review Board Statement
Informed Consent Statement
Data Availability Statement
Conflicts of Interest
References
- Corcione Esposito, C.; De Simone, N.; Santarelli, M.L.; Frigione, M. Protective properties and durability characteristics of experimental and commercial organic coatings for the preservation of porous stone. Prog. Org. Coat. 2017, 103, 93–203. [Google Scholar] [CrossRef]
- Hansen, E.F.; Agnew, N. Consolidation with moisture curable isocyanates: Polyureas and polyurethanes. In Proceedings of the Ninth Triennial Meeting of the ICOM Committee for Conservation; ICOM Committee for Conservation: Los Angeles, CA, USA, 1990; pp. 557–562. [Google Scholar]
- Croveri, P.; Chiavarini, M. Fassina, V., Ed.; Evaluations of the effectiveness of innovative perfluoropolyurethane polymers and consolidants for porous materials. In Proceedings of the Ninth International Congress on Deterioration and Conservation of Stone; Elsevier: Amsterdam, The Netherlands, 2000; pp. 263–271. [Google Scholar]
- Giorgi, R.; Baglioni, M.; Berti, D.; Baglioni, P. New methodologies for the conservation of cultural heritage: Micellar solutions, microemulsions, and hydroxide nanoparticles. Acc. Chem. Res. 2010, 43, 696–704. [Google Scholar] [CrossRef] [PubMed]
- Carretti, E.; Dei, L. Physicochemical characterization of acrylic polymeric resins coating porous materials of artistic interest. Prog. Org. Coat. 2004, 49, 282–289. [Google Scholar] [CrossRef]
- Favaro, M.; Menichelli, C.; Ossola, F.; Russo, U.; Simon, S.; Tomasin, P.; Vigato, P.A. Evaluation of polymers for conservation treatments of outdoor exposed stone monuments. Part I: Photo-oxidative weathering. Polym. Degrad. Stab. 2006, 91, 3083–3096. [Google Scholar] [CrossRef]
- Zhang, H.; Liu, Q.; Liu, T.; Zhang, B. The preservation damage of hydrophobic polymer coating materials in conservation of stone relics. Prog. Org. Coat. 2013, 76, 1127–1134. [Google Scholar] [CrossRef]
- Sabatini, V.; Cattò, C.; Cappelletti, G.; Cappitelli, F.; Antenucci, S.; Farina, H.; Ortenzi, M.A.; Camazzola, S.; Di Silvestro, G. Protective features, durability and biodegradation study of acrylic and methacrylic fluorinated polymer coatings for marble protection. Prog. Org. Coat. 2018, 114, 47–57. [Google Scholar] [CrossRef]
- Sterflinger, C.; Piñar, G. Microbial deterioration of cultural heritage and works of art—Tilting at windmills? Appl. Microbiol. Biotechnol. 2013, 97, 9637–9646. [Google Scholar] [CrossRef]
- Florian, M.L.E. Fungal Facts, Solving Fungal Problems in Heritage Collections; Archetype Publication Ltd.: London, UK, 2002. [Google Scholar]
- Vukojeviç, J.; Grbiç, M.L. Moulds on paintings in Serbian fine art museums. Afr. J. Microbiol. Res. 2010, 4, 1453–1456. [Google Scholar]
- Gu, J.D. Microbiological deterioration and degradation of synthetic polymeric materials: Recent research advances. Int. Biodeter. Biodegrad. 2003, 52, 69–91. [Google Scholar] [CrossRef]
- Zander, Z.; Newton, D.; Scaglione, H.; Reiber, A.; Agarwal, P. Microbial susceptibility of various polymers and evaluation of thermoplastic elastomers with antimicrobial additives. Polym. Eng. Sci. 2021, 61, 3029–3036. [Google Scholar] [CrossRef]
- Cappitelli, F.; Sorlini, C. Microorganisms attack synthetic polymers in items representing our cultural heritage. Appl. Environ. Microbiol. 2008, 74, 564–569. [Google Scholar] [CrossRef] [PubMed]
- Stuart, B.H. Infrared Spectroscopy: Fundamentals and Applications; John Wiley & Sons, Ltd.: Hoboken, NJ, USA, 2004; ISBN 9780470854273. Available online: https://onlinelibrary.wiley.com/doi/book/10.1002/0470011149 (accessed on 5 September 2022).
- Cappitelli, F.; Principi, P.; Pedrazzani, R.; Toniolo, L.; Sorlini, C. Bacterial and fungal deterioration of the Milan Cathedral marble treated with protective synthetic resins. Sci. Total Environ. 2007, 385, 172–181. [Google Scholar] [CrossRef]
- Cappitelli, F.; Nosanchuk, J.D.; Casadevall, A.; Toniolo, T.; Brusetti, L.; Florio, S.; Principi, P.; Borin, S.; Sorlini, C. Synthetic consolidants attacked by melanin-producing fungi: Case study of the biodeterioration of Milan (Italy) cathedral marble treated with acrylics. Appl. Environ. Microbiol. 2007, 73, 271–277. [Google Scholar] [CrossRef]
- Cappitelli, F.; Zanardini, E.; Sorlini, C. The biodeterioration of synthetic resins used in conservation. Macromol. Biosci. 2004, 4, 399–406. [Google Scholar] [CrossRef] [PubMed]
- Gu, J.D. Biodegradation testing: So many tests but very little new innovation. Appl. Environ. Biotechnol. 2016, 1, 92–95. [Google Scholar] [CrossRef]
- Caneva, M.P.; Nugari, O.; Salvadori, O. La Biologia Vegetale per i Beni Culturali; Vol 1, Biodeterioramento e Conservazione; Nardini Editore: Florence, Italy, 2007. [Google Scholar]
- Lugauskas, A.; Levinskaité, L.; Pečiulyté, D. Micromycetes as deterioration agents of polymeric material. Int. Biodeter. Biodegrad. 2003, 52, 233–242. [Google Scholar] [CrossRef]
- Dufossé, L.; Caro, Y.; Fouillaud, M. Fungal pigments: Deep into the rainbow of colorful fungi. J. Fungi 2017, 3, 45. [Google Scholar] [CrossRef]
- Lo Schiavo, S.; De Leo, F.; Urzì, C. Present and future perspectives for biocides and antifouling products for stone-built cultural heritage: Ionic liquids as a challenging alternative. Appl. Sci. 2020, 10, 6568. [Google Scholar] [CrossRef]
- Herman, A.; Aerts, O.; deMontjoye, L.; Tromme, I.; Goossens, A.; Baeck, M. Isothiazolinone derivatives and allergic contact dermatitis: A review and update. J. Eur. Acad. Dermatol. Venereol. 2019, 33, 267–276. [Google Scholar] [CrossRef]
- Shirakawa, M.A.; Gaylarde, C.C.; Gaylarde, P.M.; John, V.; Gambale, W. Fungal colonization and succession on newly painted buildings and the effect of biocide. FEMS Microbiol. Ecol. 2002, 39, 165–173. [Google Scholar] [CrossRef]
- Abdel-Kareem, O. The long-term effect of selected conservation materials used in the treatment of museum artifacts on some properties of textiles. Polym. Degrad. Stab. 2005, 87, 21–130. [Google Scholar] [CrossRef]
- Martin-Sanchez, P.M.; Nováková, A.; Bastian, F.; Alabouvette, C.; Saiz-Jimenez, C. Use of biocides for the control of fungal outbreaks in subterranean environments: The case of the Lascaux Cave in France. Environ. Sci. Technol. 2012, 46, 3762–3770. [Google Scholar] [CrossRef] [PubMed]
- Krumbein, W.E.; Gross, M. Interactions of biocides with cultures of biodeteriorating microbiota in agar diffusion and rock tube tests. In Proceedings of the Fifth International Congress on Deterioration and Conservation of Stone, Laboratorio Nacional de Engenharia Civil, Lisbon, Portugal, 15–18 June 1992; pp. 501–509. [Google Scholar]
- Rajkowska, K.; Koziróg, A.; Otlewska, A.; Piotrowska, M.; Nowicka-Krawczyk, P.; Brycki, B.; Kunicka-Styczyńska, A.; Gutarowska, B. Quaternary ammonium biocides as antimicrobial agents protecting historical wood and brick. Acta Biochim. Pol. 2016, 63, 153–159. [Google Scholar] [CrossRef] [PubMed]
- He, Y.; Xie, K.; Xu, P.; Huang, X.; Gu, W.; Zhang, F.; Tang, S. Evolution of microbial community diversity and enzymatic activity during composting. Res. Microbiol. 2013, 164, 189–198. [Google Scholar] [CrossRef]
- Mohammadi, K.; Heidari, G.; Khalesro, S.; Sohrabi, Y. Soil management, microorganisms and organic matter interactions: A review. Afr. J. Biotechnol. 2011, 10, 19840–19849. [Google Scholar] [CrossRef]
- Pathak, V.M.; Navneet. Review on the current status of polymer degradation: A microbial approach. Bioresour. Bioprocess 2017, 4, 15. [Google Scholar] [CrossRef]
- Dey, U.; Mondal, N.K.; Das, K.; Dutta, S. An approach to polymer degradation through microbes. IOSR J. Pharm. 2012, 2, 385–388. [Google Scholar]
- Arp, D.J.; Yeager, C.M.; Hyman, M.R. Molecular and cellular fundamentals of aerobic cometabolism of trichloroethylene. Biodegradation 2001, 12, 81–103. [Google Scholar] [CrossRef]
- Tran, N.H.; Urase, T.; Ngo, H.H.; Hu, J.; Ong, S.L. Insight into metabolic and cometabolic activities of autotrophic and heterotrophic microorganisms in the biodegradation of emerging trace organic contaminants. Bioresour. Technol. 2013, 146, 721–731. [Google Scholar] [CrossRef]
- Doménech-Carbó, M.T.; Bitossi, G.; Osete-Cortina, L.; Yusá-Marco, D.J.; Bolívar-Galiano, F.; del Mar López Miras, M.; Fernández-Vivas, M.A.; Martín-Sánchez, I. Introduction to the study on the biodeterioration of the poly(vinyl) acetate resin Mowilith 50 using FTIR spectroscopy and pyrolysis-gas chromatography-mass spectrometry. Arché 2007, 2, 109–114. [Google Scholar]
- McNamara, C.J.; Breuker, M.; Helms, M.; Perry, T.D.; Mitchell, R. Biodeterioration of Incralac used for the protection of bronze monuments. J. Cult. Herit. 2004, 5, 361–364. [Google Scholar] [CrossRef]
- Baglioni, P.; Carretti, E.; Chelazzi, D. Nanomaterials in art conservation. Nat. Nanotechnol. 2015, 10, 287–290. [Google Scholar] [CrossRef] [PubMed]
- David, M.E.; Ion, R.M.; Grigorescu, R.M.; Iancu, L.; Andrei, E.R. Nanomaterials used in conservation and restoration of cultural heritage: An up-to-date overview. Materials 2020, 13, 2064. [Google Scholar] [CrossRef] [PubMed]
- Arkaban, H.; Barani, M.; Akbarizadeh, M.R.; Pal Singh Chauhan, N.; Jadoun, S.; Dehghani Soltani, M.; Zarrintaj, P. Polyacrylic Acid Nanoplatforms: Antimicrobial, Tissue Engineering, and Cancer Theranostic Applications. Polymers 2022, 14, 1259. [Google Scholar] [CrossRef]
- Schettini, A.; Fatigati, G.; Cennamo, P.; Moretti, A. Identification and removal of biodeteriogens on a polychrome wood sculpture. Delpinoa 2010, 52–53, 47–56. [Google Scholar]
- Sabatini, L.; Sisti, M.; Campana, R. Evaluation of fungal community involved in the bioderioration process of wooden artworks and canvases in Montefeltro area (Marche, Italy). Microb. Res. 2018, 207, 203–210. [Google Scholar] [CrossRef]
- Clinical and Laboratory Standards Institute (CLSI). M07-A10: Methods for Dilution Antimicrobial Susceptibility Tests for Bacteria that Grow Aerobically, 10th ed.; Clinical and Laboratory Standards Institute: Wayne, PA, USA, 2017; p. 66. [Google Scholar]
- ASTM G21-96; Standard Practice for Determining Resistance of Synthetic Polymeric Materials to Fungi. American Society for Testing and Materials (ASTM International): West Conshohocken, PA, USA, 2002.
- ASTM G22-76; Standard Practice for Determining Resistance of Plastics to Bacteria. American Society for Testing and Materials (ASTM International): West Conshohocken, PA, USA, 1996.

| Resins | Growth of P. aeruginosa ATCC 9027 | ||
|---|---|---|---|
| 7 Days | 14 Days | 21 Days | |
| AC 012 with biocide | Visible growth | Visible growth | Visible growth |
| AC 012 without biocide | |||
| AC 013 with biocide | Visible growth | Visible growth | Visible growth |
| AC 013 without biocide | |||
| PU H6 with biocide | Visible growth | Visible growth | Visible growth |
| PU H6 without biocide | |||
| PU GS with biocide | Visible growth | Visible growth | Visible growth |
| PU GS without biocide | |||
| PU MW2 with biocide | Visible growth | Visible growth | Visible growth |
| PU MW2 without biocide | |||
| AC P1 with biocide | Visible growth | Visible growth | Visible growth |
| AC P1 without biocide | |||
| AC 32 with biocide | Visible growth | Visible growth | Visible growth |
| AC 32 without biocide | |||
Publisher’s Note: MDPI stays neutral with regard to jurisdictional claims in published maps and institutional affiliations. |
© 2022 by the authors. Licensee MDPI, Basel, Switzerland. This article is an open access article distributed under the terms and conditions of the Creative Commons Attribution (CC BY) license (https://creativecommons.org/licenses/by/4.0/).
Share and Cite
Campana, R.; Sabatini, L.; Giorgi, L.; Pettinari, G.; Valentini, L.; Gobbi, P. A Multidisciplinary Approach in Examining the Susceptibility to Microbial Attack of Polyacrylic and Polyurethane Resins Used in Art Restoration. Int. J. Mol. Sci. 2022, 23, 11725. https://doi.org/10.3390/ijms231911725
Campana R, Sabatini L, Giorgi L, Pettinari G, Valentini L, Gobbi P. A Multidisciplinary Approach in Examining the Susceptibility to Microbial Attack of Polyacrylic and Polyurethane Resins Used in Art Restoration. International Journal of Molecular Sciences. 2022; 23(19):11725. https://doi.org/10.3390/ijms231911725
Chicago/Turabian StyleCampana, Raffaella, Luigia Sabatini, Luca Giorgi, Giulia Pettinari, Laura Valentini, and Pietro Gobbi. 2022. "A Multidisciplinary Approach in Examining the Susceptibility to Microbial Attack of Polyacrylic and Polyurethane Resins Used in Art Restoration" International Journal of Molecular Sciences 23, no. 19: 11725. https://doi.org/10.3390/ijms231911725
APA StyleCampana, R., Sabatini, L., Giorgi, L., Pettinari, G., Valentini, L., & Gobbi, P. (2022). A Multidisciplinary Approach in Examining the Susceptibility to Microbial Attack of Polyacrylic and Polyurethane Resins Used in Art Restoration. International Journal of Molecular Sciences, 23(19), 11725. https://doi.org/10.3390/ijms231911725

